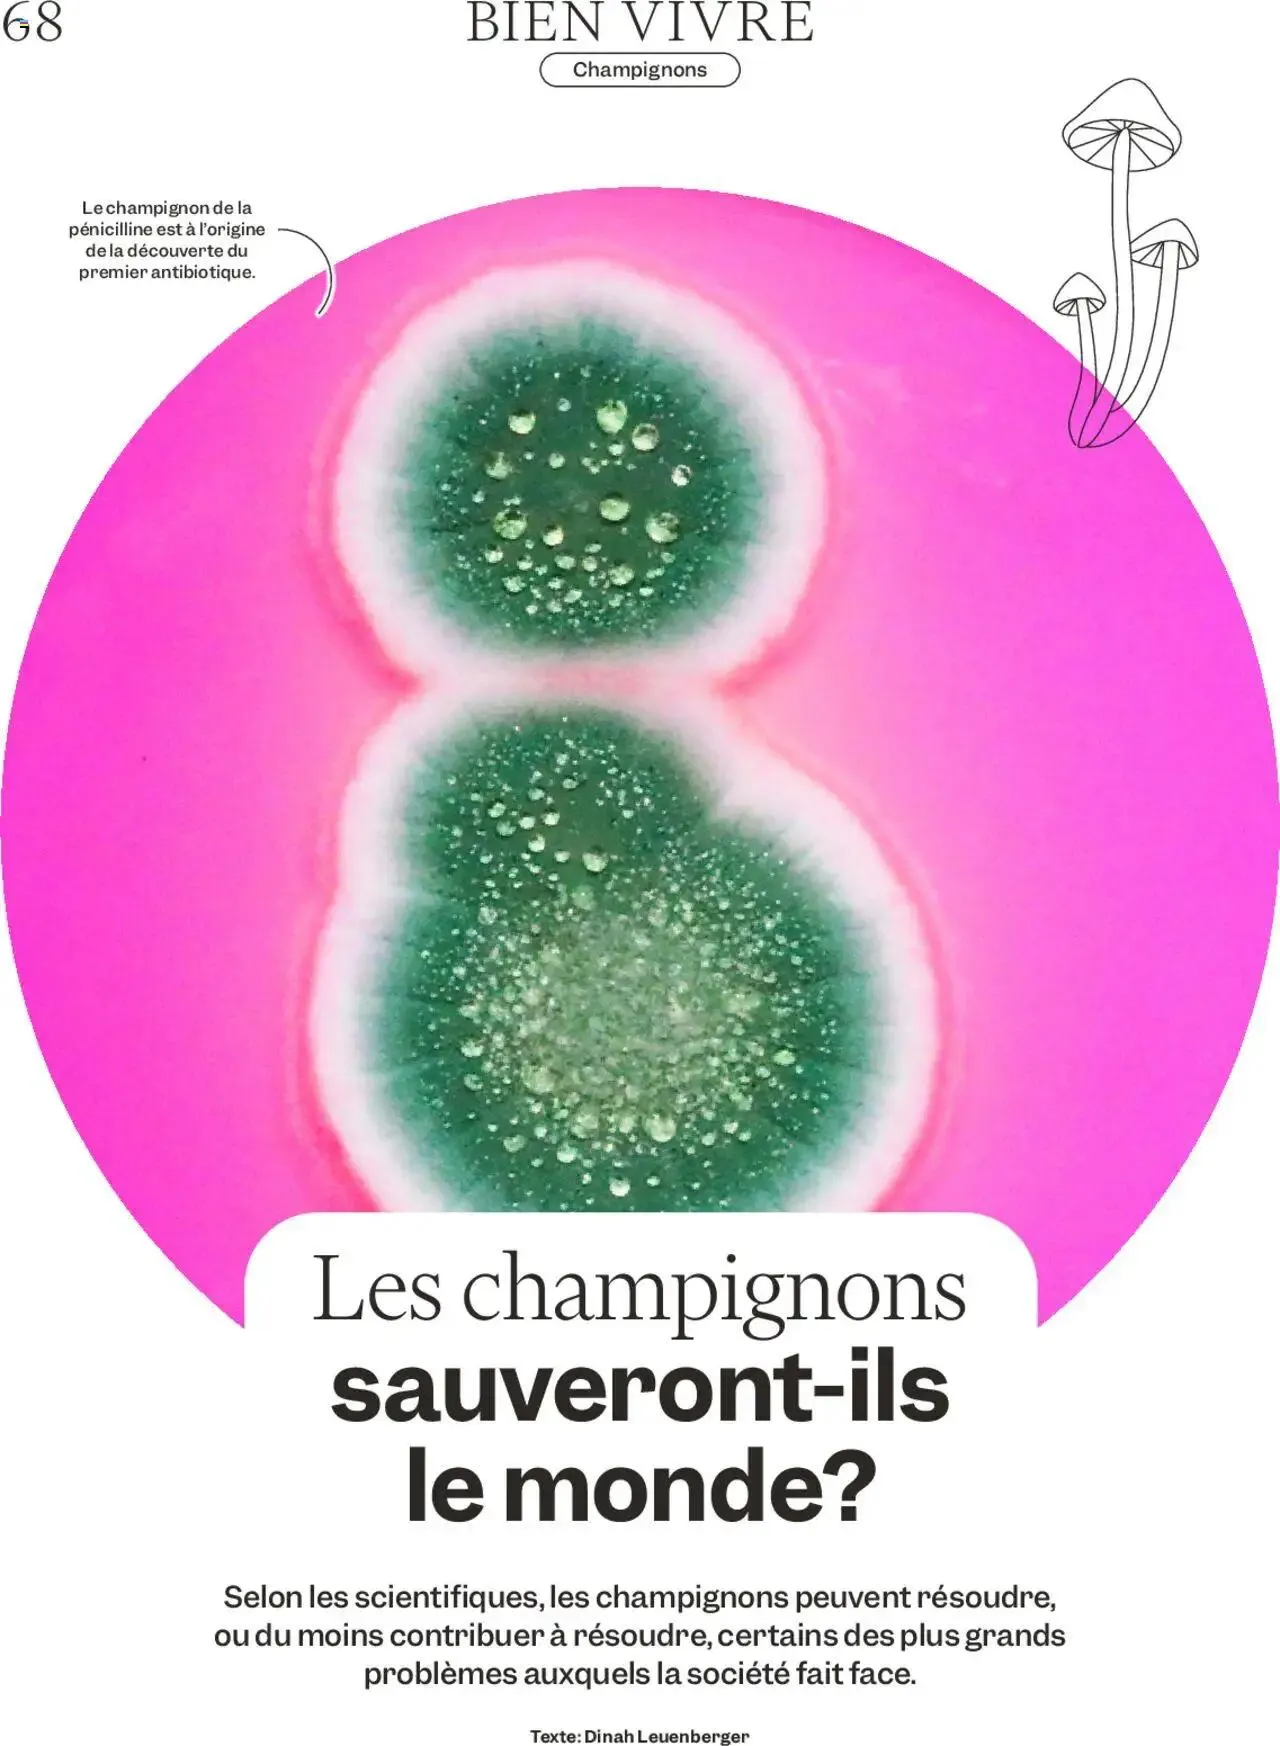
Migros Magazin FR von 21. Oktober bis 27. Oktober 2024 - Prospekt seite 68

Migros Prospekt
Gültig von 21. Oktober 2024 bis 27. Oktober 2024
Die aktuell Migros Prospekt ist da!
Der neue Migros Prospekt ist gültig von 21. Oktober 2024 bis 27. Oktober 2024.
Auf über 80 Seiten mit Angeboten, Aktionen und Rabatten findest du tolle Sparmöglichkeiten für SUPERMÄRKTE Artikel.
Bei Migros finden Sie eine große Auswahl an Produkten, Babynahrung, Kinderkleidung, Kinderwagen, Reisegepäck, Gesichtspflegeprodukte, Haarstylingprodukte, Rasiersets, Sonnenschutz, Hemden, Sweatshirts, Unterwäsche, Jacken, Mäntel, Nachtwäsche, Einkaufstaschen, Körbe, Geldbörsen, Rucksäcke, Regenschirme, Schuhe, Sonnenbrillen, Gartenbedarf, Beleuchtung, Pappteller, Insektizide, Tischdecken, Waschmittel, Backwaren, Chips, Snacks, Fertiggerichte, Meeresfrüchte, Fleisch, Obst, Gemüse, Heißgetränke, Getränke, Molkereiprodukte, Eier, Müsli, Nudeln, Konserven, Tiefkühlprodukte, Büroartikel, Umschläge, Fotoalben, Aufbewahrungslösungen, Notizblöcke, Bleistifte und Karteikarten.
Finde einen Migros in deiner Nähe und nutze jede Vergünstigung, um das Beste für dein Geld zu bekommen. Vergiss die steigenden Preise und die hohe Inflation. bringt dir günstige Preise und einmalige Rabatte bei Migros und vielen anderen SUPERMÄRKTE Geschäften im ganzen Land.
Wir haben jeden Tag neue Prospekte, also komm bald wieder, um noch mehr Migros Angebote zu finden!